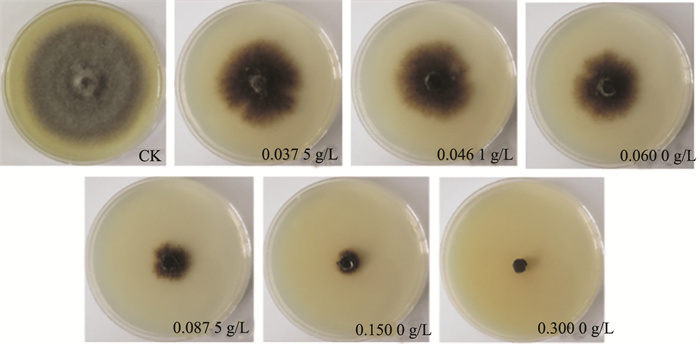
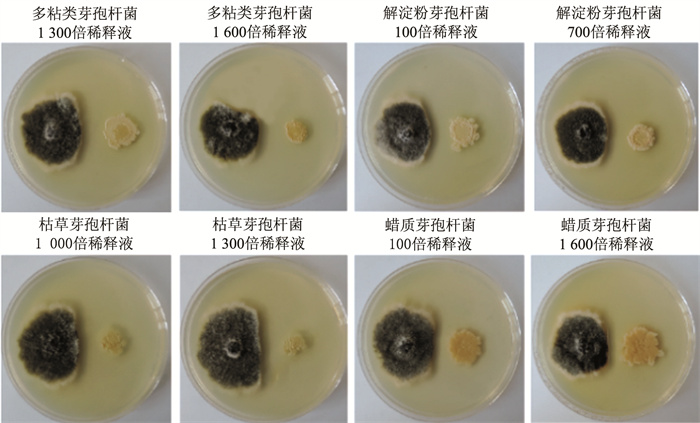

-
开放科学(资源服务)标识码(OSID):

-
蒲公英(Taraxacum mongolicum Hand.-Mazz.)别名黄花地丁、婆婆丁、华花郎等,是菊科多年生草本植物[1],药食两用,已被列为中国中药保护植物,主要分布在中国西南及华北等地[2]。蒲公英具有很高的营养价值,不仅富含蛋白质、脂肪酸、氨基酸、维生素及微量元素,还含有黄酮类、酚酸类、甾醇类、多糖类等多种功效成分[3]。有临床研究表明,蒲公英具有抑菌消炎、调节血糖、抗衰老、增强免疫力、抑制肿瘤等药理功效。其中,酚酸具有抗氧化和免疫刺激特性;倍半萜内酯具有抗炎和抗菌活性;三萜类化合物、甾醇可缓解心血管病症;类黄酮具有抗氧化活性;香豆素具有消炎抑菌、抗凝以及抑制肿瘤的作用[4-5]。近年来,随着蒲公英在食品、医药及农业领域受重视程度不断增加,市场对其产量和品质要求也愈发严格。
蒲公英叶斑病在甘肃、青海、四川等蒲公英种植区及高山草甸地区高发,危害严重。发病叶片呈现褐色病斑,个别病斑中心颜色浅、边缘颜色深,形状为圆形、椭圆形或不规则形。病害严重时,病斑连成一片,可使植株枯萎。研究表明,该病害病原菌复杂多样。张自强等[6]证实细极链格孢(Alternaria tenuissima)可引发该病。Xu等[7]研究发现Didymella uniseptata也是致病病原。Qi等[8]在青海省西宁市湟中区田家寨镇采集蒲公英叶斑病样本,发现茄链格孢(A. solani)同样可引发蒲公英叶斑病。
叶斑病作为一种常见的真菌性病害,其病原菌在不同作物中存在明显差异。例如,燕麦叶斑病主要由燕麦内脐蠕孢(Drechslra avenacea)引起,严重影响燕麦产量和品质[9];花生叶斑病主要危害叶片和茎秆,破坏叶绿素,降低光合作用,严重阻碍干物质积累和荚果成熟[10]。针对这些病害,生物防治已展现出显著效果。张睿芳等[11]研究发现,枯草芽孢杆菌对燕麦叶斑病防效最高、持效性最好。它不仅可有效抑制燕麦叶斑病,还能提高燕麦旗叶叶绿素含量、增加种子千粒重,提高产量。鄢洪海等[12]研究表明,接种丛枝菌根真菌可有效防治花生黑斑病,显著提升花生株高、分枝、荚果数等生长指标。蒲公英作为重要的药用植物,其叶斑病防治研究相对滞后。目前,国内外关于蒲公英叶斑病病原学及生物防治的系统研究较为缺乏,这在一定程度上制约了蒲公英产业的可持续发展。因此,本研究通过进一步分离、鉴定,明确引起蒲公英叶斑病的病原菌,并在室内筛选出绿色高效的生物药剂,旨在为后续蒲公英叶斑病的生物防治提供理论依据。
全文HTML
-
2022年8月在青海省西宁市湟中区田家寨镇千紫缘农业科技博览园,采集蒲公英叶斑病样本3份,放入保鲜袋保存,及时带回实验室分离病原菌。
-
2%水琼脂培养基(WA)和马铃薯葡萄糖琼脂培养基(PDA)配制参照祁鹤兴等[13]的方法。
-
研究所需生物药剂见表 1。
-
首先,从蒲公英病害样本的病健交界处剪取0.5 cm×0.5 cm大小的组织块,置于3.5%次氯酸钠溶液中消毒1 min,然后用无菌水冲洗3次,放到无菌滤纸上吸干多余水分,完成样本的表面消毒。
然后,将消毒好的组织块放在含0.1%氨苄青霉素的水琼脂平板上,放入25 ℃恒温培养箱中培养36 h。待长出菌丝后,用无菌水将其洗下并制成浓度为2×104个/mL的孢子悬浮液,用移液枪吸取孢子悬浮液200 μL,均匀涂布到2%水琼脂平板上,在超净台内吹干,放入25 ℃培养箱中培养,等孢子萌发之后,用无菌挑针在显微镜下挑取已经萌发的单个分生孢子置于PDA平板上,待长出菌落后进行纯化培养。
最后,将分离得到的菌株采用滤纸片保存法保藏,置于20 ℃冰箱长期保存[14]。
-
在PDA培养基上接种分离得到的菌株,放入25 ℃恒温培养箱中培养6 d,用直径0.5 cm的灭菌打孔器截取平板上的菌饼,置于PDA平板中央,每个菌株重复3次,并确保每一皿PDA培养基的厚度一致,再次放入25 ℃培养箱中培养6 d后,观察分析其菌落形态特征。
-
DNA的提取参照常建萍等[15]的方法,采用CATB法提取目标菌株DNA后,置于-20 ℃保存。
PCR扩增及其测序,菌株序列分析扩增引物见表 2。
PCR反应体系(25 μL)为:2×PCR Mix(Takara)12.5 μL;引物1(25 pmol)1.0 μL;引物2(25 pmol)1.0 μL;DNA模板1 μL;超纯水25 μL。
PCR产物用0.8%琼脂糖凝胶电泳检测。PCR扩增产物纯化后送到北京擎科生物技术有限公司进行正反向引物双向测序。使用MAFFT软件对正反向序列进行拼接,拼接后用MEGA V.6.0.6软件进行校正,再用PAUP*v.4.0 alpha软件构建系统发育树,在构建过程中选用了启发式算法进行运算。运算重复1 000次以确保结果的准确性。参考菌株序列从NCBI数据库中下载。菌株PS-3-1-1 NCBI登录号为PV382376(ITS)、PV248648(LSU)、PV391878(Tub2);菌株PS-3-1-2 NCBI登录号为PV382377(ITS)、PV248649(LSU)、PV391879(Tub2);菌株PS-3-1-3 NCBI登录号为PV382378(ITS)、PV248650(LSU)、PV391880(Tub2)。
-
将菌株接种至PDA培养基平板,在25 ℃恒温条件下培养7 d。在直径为12 cm的塑料花盆里填充营养土,将育种盘中的蒲公英移栽至花盆,待其在花盆中生长30 d后开始接种,接种试验重复3次。采用2种接种方法测定病原菌的致病性[18],具体操作如下:
离体接种法:将蒲公英从盆里移出,用无菌水将根部清洗干净后,整株放入10 cm玻璃皿内。实验组将菌丝块接种到蒲公英叶片上,对照组将无菌水接种至蒲公英叶片上。接种完成后,将玻璃皿置于25 ℃黑暗条件下保湿培养24 h,随后在25 ℃光照条件下培养5 d。接种发病期间,密切观察蒲公英叶片的发病情况。
喷雾接种法:用10 mL 0.025%的吐温20溶液清洗菌丝,制备成菌丝悬浮液。用无菌棉签将菌丝悬浮液均匀地涂抹在蒲公英叶片上,每盆植株涂抹2次。接种完成后,将花盆置于25 ℃的黑暗条件下保湿培养24 h,随后在25 ℃的持续光照条件下培养6 d。接种期间,密切关注蒲公英叶片的发病情况并记录。每株菌株接种3盆蒲公英,重复3次。
-
采用菌丝生长抑制法测定仿生物提取物类杀菌剂对病原菌的抑制作用[19]。首先,根据不同仿生物提取物类杀菌剂的有效成分含量,计算出药剂质量浓度,制成母液。配置含药平板时,按照不同浓度吸取相应量母液,加入PDA培养基后倒置平板,保持平板厚度一致,每个浓度设置3次重复。对照组在培养基内加入等量无菌水。随后,将直径为0.5 cm的菌饼接到含药平板中央,放到25 ℃的培养箱中培养7 d。最后,用十字交叉法测量含药培养基中菌落生长的直径以及对照组菌落的直径,根据两者之间的差值判断该种药剂在不同浓度下对该菌株的抑制作用。
将测量的数据用SPSS、EXCEL软件进行处理,求得b值±标准差、抑制中浓度(EC50)、95%置信区间、卡方值和p值。
-
采用对峙培养法测定拮抗菌类抑菌剂对病原菌的抑制作用[20]。首先,准确称取拮抗菌类抑菌剂药品,加到EP管中,再加入一定体积的无菌水对药品进行稀释,稀释倍数分别为100、400、700、1 000、1 300、1 600倍,将不同稀释倍数的试管充分混合均匀,即得到药品母液。然后,用移液枪吸取10 μL拮抗菌类抑菌剂母液接到平板的一侧,将直径为0.5 cm的菌饼接到平板另一侧与药品相对应的位置。保持平板厚度一致,每个稀释倍数设置3次重复。将平板放到25 ℃的培养箱中培养7 d,测量抑菌带,根据抑菌带的大小判断该种药剂在不同浓度下对该菌株的抑制作用。
1.1. 材料来源
1.2. 培养基
1.3. 生物药剂
1.4. 病原菌的分离、纯化与保存
1.5. 病原菌的分类鉴定
1.5.1. 菌株形态学鉴定
1.5.2. 菌株分子生物学鉴定
1.6. 病原菌致病性测定
1.7. 蒲公英叶斑病防治生物药剂室内筛选
1.7.1. 仿生物提取物类杀菌剂抑制作用测定
1.7.2. 拮抗菌类抑菌剂抑制作用测定
-
2022年8月,在青海省西宁市湟中区田家寨镇千紫缘农业科技博览园发现蒲公英发生叶斑病,病斑为圆形至椭圆形,呈浅褐色至深褐色(图 1)。从蒲公英样本中共分离得到3株真菌,编号分别为PS-3-1-1、PS-3-1-2和PS-3-1-3。采用柯赫氏法则进行回接验证,3株菌株均对蒲公英叶片有致病性(图 2),且其形态特征一致,气生菌丝灰绿色至墨绿色,中间颜色较深,边缘颜色浅,分生孢子无色,呈椭圆形或梭形,无隔膜(图 3)。
对3株病原菌进行分子生物学鉴定,将所测得代表菌株的ITS、tub2和LSU基因序列在GenBank中与已知序列进行BLAST相似性比较分析,以已在NCBI公布序列的菌株为参考菌株,联合构建系统发育树。结果显示:PS-3-1-1、PS-3-1-2、PS-3-1-3与菊花花枯病菌(Stagonosporopsis chrysanthemi)以100%的支持率聚为一个分支;与其他3种拟壳多胞菌属真菌Stagonosporopsis lupini、S. rudbeckiae、S. chrysanthemila属于不同的发育分支(图 4)。因此,结合病原菌的形态特征和分子生物学鉴定结果,将3株病原菌鉴定为菊花花枯病菌。
-
采用菌丝生长抑制法测定5种仿生物提取物类杀菌剂对蒲公英叶斑病菌茄链格孢和菊花花枯病菌的敏感性(图 5),发现苦参碱对茄链格孢和菊花花枯病菌的抑制效果最好,EC50值分别为0.050 g/L和0.042 g/L;其次是春雷霉素,对2种病原菌的抑制效果较好,EC50值分别为0.109 g/L和0.248 g/L;氨基寡糖素抑制茄链格孢和菊花花枯病菌效果较差,EC50值分别为0.693 g/L和0.572 g/L(表 3)。
-
采用皿内对峙培养法测定4种拮抗类生物抑菌剂对蒲公英叶斑病菌茄链格孢和菊花花枯病菌抑菌效果(图 6)。发现多粘类芽孢杆菌对茄链格孢和菊花花枯病菌的抑制效果最好,抑菌带宽度均在0.80 cm和1.00 cm以上。其次是解淀粉芽孢杆菌,对茄链格孢抑菌带宽带为0.73~0.87 cm,对菊花花枯病菌抑菌带宽带为1.13~1.70 cm。枯草芽孢杆菌对菊花花枯病菌抑制效果较好,抑菌带宽度为0.97~1.57 cm。蜡质芽孢杆菌对茄链格孢和菊花花枯病菌抑菌效果较差,对茄链格孢抑菌带宽度在0.20~0.47 cm,对菊花花枯病菌抑菌带宽度在0.53~0.73 cm(表 4)。
2.1. 蒲公英叶斑病菌的鉴定
2.2. 蒲公英叶斑病生物防治药剂室内筛选
2.2.1. 病原菌对仿生物提取物类杀菌剂的敏感性
2.2.2. 病原菌对拮抗菌类抑菌剂的敏感性
-
本研究发现菊花花枯病菌(Stagonosporopsis chrysanthemi)能引起蒲公英叶斑病。菊花花枯病菌隶属于子囊菌门(Ascomycota)、座囊菌纲(Dothideomycetes)、格孢腔菌目(Pleosporales)、亚隔孢壳科(Didymellaceae)[21]。该属真菌大多种类为植物病原菌,其中S. ligulicola、S. dorenboschii、S. heliopsidis和S. rudbeckiae等多种病原菌能引起菊科植物的枯萎病、叶斑病和花斑病[22]。病害发生后,在菊科植物的叶、茎部出现不同的病害症状,导致植物生长受阻,严重时甚至死亡。S. citrull、S. cucurbitacearum和S. caricae等病原菌能引起瓜类蔓枯病[23],该病害具有发病早、危害重等特点,对瓜类作物的安全生产造成了严重威胁。2023年,有研究者报道广西贺州烟草叶斑病由Stagonosporopsis vannaccii引起[24]。因此,此类病害应引起人们的重视,加强病害防控工作。
结合本研究结果和课题组前期研究发现,青海省西宁市湟中县田家寨镇蒲公英叶斑病菌有链格孢属茄链格孢和菊花花枯病菌。链格孢属真菌种类多且寄主范围广,长期以来对农作物的产量和品质造成了恶劣影响[25-26]。2021年,有研究发现黑龙江哈尔滨蒲公英紫斑病由极细链格孢引起[27]。
Kaewkham等[28]通过枯草芽孢杆菌处理黄瓜种子,有效降低了黄瓜蔓枯病的发病率。吴颖等[29]在防治由茄链格孢引起的番茄早疫病时,筛选出3株芽孢杆菌,即地衣芽孢杆菌(Bacillus licheniformis)、解淀粉芽孢杆菌(B. amyloliquefaciens)、枯草芽孢杆菌(B. subtilis),其对茄链格孢菌丝的生长均有一定的抑制作用。还有研究发现,枯草芽孢杆菌、解淀粉芽孢杆菌还能有效防治玉米茎腐病[30]。春雷霉素属氨基糖苷类抗生素,由春日链霉菌(Streptomyces kasugaensis)和小金色链霉菌(S. microaureus)分泌,已被广泛用于稻瘟病的防控[31]。王柯[32]研究发现,在多年苹果园土壤添加0.1‰苦参碱后,土壤中串珠镰孢菌(Fusarium moniliforme)和尖孢镰孢菌(F. oxysporum)的基因拷贝数降低,真菌数量明显减少。这些研究为农作物病害的绿色防控提供了多样的资源和生物制剂选择,具有重要的理论和实践意义。
本研究首次报道了菊花花枯病菌可引起蒲公英叶斑病,聚焦仿生物提取物类杀菌剂和拮抗菌类抑菌剂,分别探究了它们对茄链格孢和菊花花枯病菌的抑制作用。在仿生物提取物类杀菌剂中,苦参碱对茄链格孢和菊花花枯病菌的抑制效果最好;在拮抗菌类抑菌剂中,多粘类芽孢杆菌对茄链格孢和菊花花枯病菌的抑制效果最好,枯草芽孢杆菌次之。这些发现加深了我们对现有抑菌资源的认识。随着人们对生态环境保护的关注度不断提高,生物防治在农业领域的应用前景十分广阔,未来有望通过技术创新,进一步提高防治效果,为可持续发展做出更大贡献。




 下载:
下载: